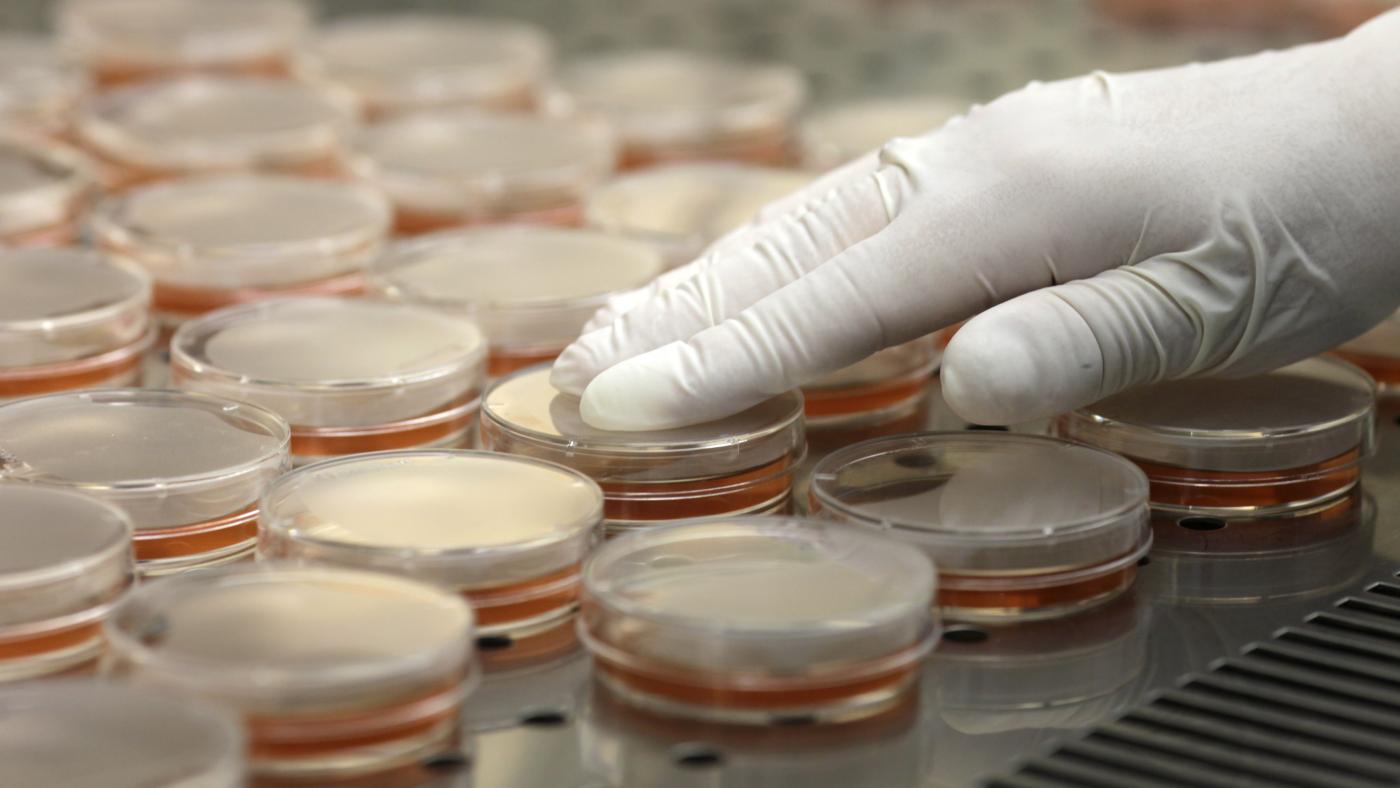

Гигантский и очень крутой материал The Verge про трансгуманизм в целом (в самом широком понимании — про людей, которые верят, что технологии сделают нас чем-то большим, чем просто люди, а ещё помогут победить смерть) и про удивительного человека по имени Золтан Истван, который собирается баллотироваться в президенты США от Трансгуманистической Партии (правда, он вроде верит, что на этих выборах не сможет победить, а победит в 2024-м).
С одной стороны, это довольно мощное исследование, что такое трансгуманизм в 2015 году — тут много мелких подробностей, отдельная страница с таймлайном, всякие примеры, как люди пытаются победить смерть (и их спонсируют корпорации) и так далее.
С другой, история про удивительного персонажа: автор отправляется с Истваном в роуд-трип по Америке (конечная цель которого — представить Конгрессу трансгуманистический Билль о правах) в крохотном вэне — ещё с ними едет 28-летний хиппи и мутный русский мужик по имени Алексей, начальник которого пожертвовал кучу денег на кампанию Золтана Иствана на Indiegogo.
Совершенно непонятно, насколько Истван серьёзно верит в трансгуманизм и технологическое бессмертие, а насколько просто развлекается. Он такой классический шарлатан: белобрысый сёрфер, который дико любит жизнь и пышит энергией — абсолютный Бодхи из «На гребне волны». При этом всё путешествие по Америке, кажется, он затеял только ради того, чтобы про него журналисты написали. И он очень круто с журналисткой The Verge играет в такую игру: совершенно явно осознанно создаёт крутые ситуации для репортажа (там есть момент, когда они пересекают границу между США и Мексикой просто, чтобы купить тако, например) — и журналистка явно всё понимает и как бы ведётся, но при этом пишет так, чтобы было понятно, что это игра. В общем, ужасно увлекательный текст.
http://www.theverge.com/a/transhumanism-2015